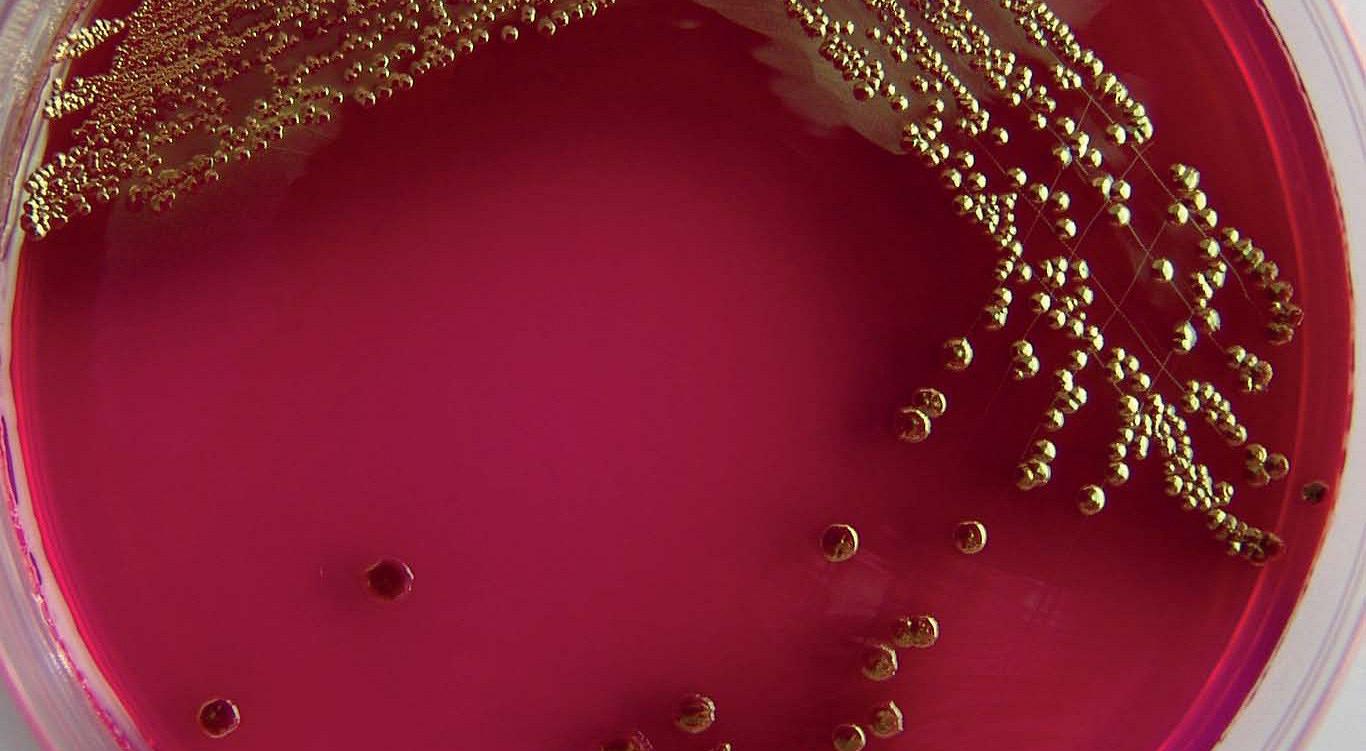

Urineweginfecties
Urineweginfecties komen veel voor in de huisartsenpraktijk en zijn doorgaans onschuldig bij gezonde volwassenen. Bij specifieke risicogroepen – zoals mannen, kinderen, zwangeren, diabeten, patiënten met verminderde weerstand of urologische afwijkingen – kan de infectie echter een ernstiger beloop hebben. Het is daarom van groot belang deze patiënten tijdig te herkennen en adequaat te behandelen. In deze nascholing staat de herziene NHG-Standaard Urineweginfecties (juni 2013) centraal. Daarin is de klassieke indeling in gecompliceerde en ongecompliceerde infecties verlaten. In plaats daarvan wordt gewerkt met risicogroepen, waarvoor ook aangepaste behandeladviezen gelden. De e-learning besteedt aandacht aan het vaststellen van risicogroepen, het betrouwbaar uitvoeren van urinediagnostiek en het inzetten van aanvullend onderzoek indien nodig. Ook worden de veranderingen in eerstekeusantibiotica per patiëntencategorie besproken. Door vertrouwd te raken met de nieuwe richtlijnen en werkwijze, versterkt u uw competentie in het bieden van gerichte en effectieve zorg bij urineweginfecties. Deze nascholing helpt u om met meer zekerheid en onderbouwd beleid om te gaan met een van de meest voorkomende infectieuze problemen in de eerstelijnszorg.
Leerdoelen
Na het bestuderen van deze collectie:
- weet u globaal hoe vaak urineweginfecties voorkomen bij de verschillende leeftijdsgroepen
- hebt u globaal kennis van de oorzaken van urineweginfecties en van de verschillen tussen mannen, vrouwen en kinderen
- weet u dat bij kinderen koorts het enige symptoom kan zijn van een urineweginfectie
- weet u welke patiënten tot een risicogroep behoren
- weet u hoe de patiënt urine op moet vangen en bewaren
- weet u hoe u een urineweginfectie nauwkeurig diagnosticeert
- weet u bij welke risicogroepen lichamelijk onderzoek aanbevolen wordt en waar dan op gelet moet worden
- kunt u goede voorlichting en adviezen geven aan patiënten met een urineweginfectie